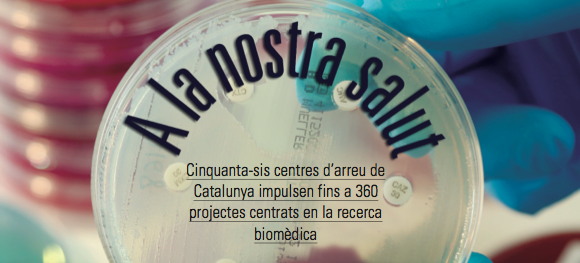
Dossier Presència: Recerca biomèdica

Exposicions
La Sala d'Art Bellmirall exhibeix la col·lectiva "16 pètals i Bells miralls"

bonart
girona - 11/06/15
Del 12 de juny al 10 de juliol, la Sala d'Art Bellmirall (carrer Bellmirall, 3, Girona) presenta la mostra col·lectiva 16 pètals i Bells miralls.
L'exposició acull les obres de tres artistes. Les pintures i escultures de Marta Montcada, basades en els elements naturals (aigua i pedra) que s'han convertit en motius essencials en les seves creacions, així com les composicions pictòriques de Vicenta Nevado, que evoquen les seves vivències personals.
A més, es projectarà la videoinstal·lació de XGUIX, 4 dones bells miralls, que ofereix una proposta inèdita als sentits i les emocions mitjançant les imatges, eina de treball del món de l'artista visual i sonor XGUIX.
L'exposició s'inaugura el 12 de juny a les 19,30h.
A la imatge, una obra de Vicenta Nevado.